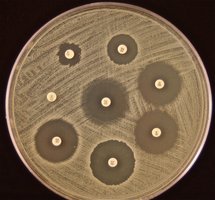
Kirby-Bauer test showing zones of inhibition

Back
BackAntimicrobial Drugs and Antibiotic Resistance: Microbiology Study Guide
Study Guide - Smart Notes

Antimicrobial Drugs
History and Sources of Antibiotics
Antibiotics are substances produced by microorganisms that inhibit the growth of other microbes. Their discovery revolutionized medicine, but only a few are of significant medical or commercial value. Most antibiotics are derived from soil-dwelling bacteria, especially Streptomyces, as well as from endospore-forming bacteria like Bacillus and molds such as Penicillium and Cephalosporium.
Antibiotic: A chemical produced by microorganisms that inhibits other microbes.
Streptomyces: Major source of antibiotics.
Bacillus: Produces antibiotics like bacitracin.
Penicillium: Source of penicillin.

General Characteristics of Antimicrobial Drugs
Antimicrobial drugs must exhibit selective toxicity, targeting microbes while minimizing harm to the host. Their effectiveness varies:
Narrow spectrum: Effective against specific bacteria.
Broad spectrum: Effective against a wide range of bacteria.
Bactericidal: Kills bacteria.
Bacteriostatic: Inhibits bacterial growth.
Major Modes of Action
Antimicrobial drugs act by targeting essential microbial processes:
Inhibiting cell wall synthesis
Inhibiting protein synthesis
Injuring the plasma membrane
Inhibiting nucleic acid synthesis
Inhibiting synthesis of essential metabolites

Inhibitors of Cell Wall Synthesis
Penicillins and Related Antibiotics
Antibiotics that inhibit cell wall synthesis prevent the formation of peptidoglycan, affecting actively growing cells. Human cells lack cell walls, so these drugs are selectively toxic.
Penicillins: Over 50 related antibiotics, all containing a β-lactam ring. They prevent cross-linking of peptidoglycans.
Carbapenems, Monobactams, Cephalosporins: Other β-lactam antibiotics with broad or narrow spectra.
Bacitracin: Polypeptide antibiotic, used topically.
Vancomycin: Glycopeptide antibiotic, used for MRSA; resistance is emerging (VRE).

Inhibitors of Protein Synthesis
Classes and Mechanisms
These antibiotics target the bacterial ribosome, interfering with protein production.
Chloramphenicol: Inhibits peptide bond formation at the 50S ribosomal subunit; broad spectrum but can suppress blood cell formation.
Aminoglycosides: Change the shape of the 30S subunit, causing misreading of genetic code (e.g., streptomycin, neomycin).
Tetracyclines: Prevent tRNA attachment at the 30S subunit; broad spectrum.
Macrolides: Attach to the 50S subunit; erythromycin is a common example.
Streptogramins, Oxazolidinones, Pleuromutilins: Newer classes targeting protein synthesis, often used for resistant bacteria.
Injury to the Plasma Membrane
Lipopeptides and Polymyxins
These drugs disrupt the bacterial membrane, causing cell death.
Daptomycin: Used for MRSA, acts on gram-positive bacteria.
Polymyxin B: Effective against gram-negative bacteria, used topically.
Bacitracin and Polymyxin B: Often combined in ointments.
Inhibitors of Nucleic Acid Synthesis
Rifamycins and Quinolones
These antibiotics block DNA or RNA synthesis.
Rifamycins: Inhibit mRNA synthesis; rifampin is used for tuberculosis and leprosy.
Quinolones/Fluoroquinolones: Inhibit DNA gyrase, preventing DNA replication (e.g., ciprofloxacin).
Competitive Inhibitors of Essential Metabolite Synthesis
Sulfonamides
Sulfonamides are structurally similar to PABA, blocking folic acid synthesis.
Bacteriostatic action
Trimethoprim and sulfamethoxazole: Commonly used combination.
Overview of Antibiotic Classes and Spectrum
Classification and Spectrum of Activity
Antibiotics are classified by their target and spectrum of activity.
Broad-spectrum: Affect multiple groups (e.g., tetracyclines).
Narrow-spectrum: Target specific organisms (e.g., vancomycin).



Tests to Guide Chemotherapy
Diffusion Method (Kirby-Bauer Test)
The Kirby-Bauer test assesses microbial susceptibility to antibiotics. Disks with antibiotics are placed on an agar plate inoculated with bacteria; zones of inhibition indicate effectiveness.
Larger zone: Greater sensitivity.
Smaller/no zone: Resistance.
Broth Dilution Tests
Broth dilution tests determine the minimum inhibitory concentration (MIC) and minimum lethal concentration (MLC) of antibiotics.
MIC: Lowest concentration preventing visible growth.
MLC: Lowest concentration killing the microbe.

Antibiotic Resistance
Overview and Causes
Antibiotic resistance is a major global health threat. It arises naturally but is accelerated by misuse and overuse.
Hospital-acquired infections: Many bacteria are resistant to common drugs.
MRSA, VRE, ESBLs, PRSP: Examples of multi-drug resistant organisms.
Main causes: Over-prescription, incomplete courses, agricultural use, poor hygiene, lack of new drugs.
Mechanisms of Resistance
Bacteria resist antibiotics through several mechanisms:
Enzymatic destruction or inactivation
Prevention of penetration
Alteration of target site
Rapid efflux (pumping out) of the drug

Genetic Basis of Resistance
Resistance can be inherent or acquired.
Inherent resistance: Lack of transport mechanism for antibiotic.
Acquired resistance: Mutation (vertical gene transfer) or horizontal gene transfer (conjugation, transformation, transduction).
Summary
Global Impact of Antibiotic Resistance
Antibiotic resistance threatens health, food security, and development. It leads to longer hospital stays, higher costs, and increased mortality.
Misuse accelerates resistance.
Infections like pneumonia, TB, gonorrhea, and Salmonellosis are harder to treat.
Additional info: The notes expand on mechanisms, examples, and testing methods for antimicrobial drugs and resistance, providing context for microbiology students.
